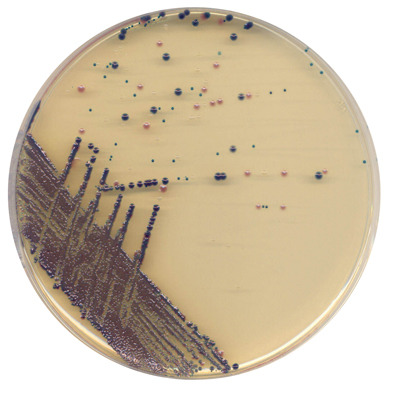

Culture shock for UTI resistance
1 Sep 2005 by Evoluted New Media
Is the decline in effectiveness of antibiotics used to treat UTIs due not only to overuse of antibiotics, but also contaminated food products?
Is the decline in effectiveness of antibiotics used to treat UTIs due not only to overuse of antibiotics, but also contaminated food products?
With almost half of all women now experiencing at least one episode of community-acquired urinary tract infection (UTI) during their lifetimes1, it is little wonder that many laboratories are finding themselves over-burdened with urine samples being submitted for microbiological analysis. While the growing use of near-patient ‘urinalysis’ technology means that negative samples are increasingly being screened out at the point of care, growth in the culturing workload for positive specimens continues unabated. The workload generated by community-acquired UTIs is further increased by samples relating to hospital-acquired UTIs, whose high incidence is increasingly associated with the use of in-dwelling catheters. Only by accurately identifying the pathogens involved can appropriate antimicrobial treatment be prescribed following susceptibility testing - yet resistance to the most commonly-prescribed antibiotics is also growing at an alarming rate.
Studies have confirmed that the spread of antibiotic resistance E.coli could be food related
UTIs affecting the lower urinary tract occur either in the urethra (urethritis) or bladder (cystitis). Those affecting the kidneys and renal pelvis in the upper part of the tract give rise to pyelonephritis. A high proportion (70% - 95%) of both upper and lower tract UTIs are caused by Escherichia coli, with organisms such as Staphylococcus saprophyticus, Proteus species, Klebsiella species, Enterococcus faecalis, other Enterobacteriaceae and yeasts accounting for the remainder. Uropathogenic bacteria, derived from a subset of faecal flora, have traits that enable adherence, growth and resistance of host defences, resulting in colonisation and infection of the urinary tract.
Many of the antibiotics which have been effective against UTIs in the past - sulfonamides, ampicillin, amoxicillin, cephalexin and tetracyclines - are steadily losing their power against these uropathogens. This is widely attributed to excessive and inappropriate use of the drugs concerned. Over the past 20 years, a combination of sulfamethoxazole and trimethoprim or trimethoprim alone have been the most commonly-prescribed therapies for E. coli-associated UTIs, but disturbing evidence is now emerging that the decline in effectiveness of these drugs may not only be attributed to excessive and inappropriate use, but may also be fuelled by widespread consumption of contaminated food products.
Food-spread resistance
Two recent studies have examined the clonal composition of E. coli isolates resistant to trimethoprim-sulfamethoxazole and concluded that their spread could be food-related. The first study2, published in the New England Journal of Medicine (NEJM) in 2001, described a previously unrecognised clonal group of uropathogenic E. coli strains known as clonal group A (CgA) that accounted for almost half of the resistant strains found in three geographically distant communities. This single clonal group was found almost simultaneously at each location in a genetically similar form, leading to suspicions that it might have been disseminated through a common source such as contaminated food products.
In a related NEJM editorial3, it was suggested that the emergence and spread of resistance to trimethoprim-sulfamethoxazole among community-acquired uropathogenic E. coli strains represents yet another example of the ongoing global problem of antimicrobial resistance. The hypothesis that these CgA strains had been food-borne gave rise to a second study4 which attempted to determine whether their origin could be traced to animals.
The authors of this subsequent study4 tested E. coli samples isolated from turkeys, cows, chickens and pigs, comparing them genetically to the strains which cause UTI in humans. Environmental samples isolated from water were also tested. Of 495 isolates tested, 26% had an enterobacterial repetitive intergenic consensus (ERIC2) PCR electrophoretic pattern indistinguishable from that of the human prototype CgA strain and 14 CgA isolates were resistant to trimethoprim-sulfamethoxazole. One of these 14 strains, isolated from a cow, was 94% similar to a CgA uropathogenic human-associated E. coli strain. The conclusion reached was that drug-resistant uropathogenic E. coli can potentially be traced to animals that are distributed as food products for human consumption.
In some regions of the United States, the prevalence of resistance to trimethoprim-sulfamethoxazole has now reached 15% - 20%, causing the Infectious Diseases Society of America to recommend that alternative antimicrobial agents should be considered for treatment of E. coli-related UTIs5.
Fluoroquinolone, ciprofloxacin and nitrofurantoin are still generally considered to be effective against most E. coli. There is, however, evidence to suggest that resistance to fluoroquinolone is also evolving in certain strains, following a similar pattern to that seen in relation to the other traditionally used anti-UTI drugs (sulfonamides, ampicillin, amoxicillin, cephalexin and tetracyclines)3. This places an even heavier burden on laboratories tasked with identifying uropathogens and assessing their antimicrobial susceptibility.
Chromogenic differentiation
Cystine-Lactose-Electrolyte Deficient (CLED) Medium has traditionally been used for culture of uropathogens, as it supports the growth of all the key organisms concerned. However, the ability of CLED to differentiate between the various organisms is limited. Those able to ferment lactose, such as E. coli, produce acid and reduce the pH of the surrounding agar causing a colour change in the medium’s bromothymol blue indicator, turning it from blue-green to yellow. MacConkey Agar is sometimes used with CLED to differentiate lactose-fermenting organisms from non-lactose-fermenting Gram-negative bacilli.
The development of a novel Chromogenic UTI Medium (available from Oxoid) has made the task of differentiation much easier. Designed to enhance the presumptive identification of the main organisms responsible for UTIs, this medium makes more extensive use of colour to differentiate between enterococci, E. coli, coliforms, S. aureus and organisms with tryptophan deaminase activity (TDA), such as Proteus, Morganella and Providencia species. The medium is clear, allowing easy tie-up between sample and identification on multiple-sample plates.
The Chromogenic UTI Medium makes differentiation of infection easier
By providing this specific and easily-visualised differentiation on a single culture plate, this new medium reduces the need for sub-culturing and further lengthy identification procedures, even when more than one species is present in the sample.
Oxoid Chromogenic UTI Medium contains two specific chromogen substrates. One is cleaved by β-glucosidase in enterococci, resulting in blue colonies, while the other is cleaved by β-glucosidase in E. coli, resulting in pink colonies. Since coliforms have the ability to cleave both chromogens, they produce purple colonies. Use of tryptophan in the medium allows for the detection of TDA activity, causing such colonies to be brown in colour, while S. aureus colonies retain their typical appearance. The production of these different colours enables laboratories to determine and report back negative samples overnight, with positives being identified and reported within 48 hours. Chromogenic reactions also make it easy for laboratories to identify samples which exhibit a mixture of organisms.
An extensive evaluation of Chromogenic UTI Medium has been carried out by members of the Department of Microbiology at University Hospital, Nottingham, who found it to provide a reliable and cost-effective alternation to CLED for the routine culture of urine specimens6. The authors of this evaluation noted a significant reduction in the number of organisms needing to be routinely processed for identification and antibiotic sensitivity testing after the chromogenic medium was introduced. Introduction of the medium in Nottingham also removed the need for the additional formal identification of organisms, reducing the number of repeat and follow-up specimens. Use of the medium has also reduced the incidence of false-positive reporting, with the consequent benefit of savings in unnecessary antimicrobial treatments6.
Thus, a change in culturing techniques could indirectly be helping to break a particularly vicious circle which is now of international concern. False-positives lead to inappropriate use of antibiotics, which in turn fuels the evolution of resistance. This is undoubtedly the main reason why pathogens, such as those implicated in UTIs, that were once easily eradicated now often prove more resistant. Ultimately, control of this situation will depend on a multidisciplinary and worldwide approach to the problem, encompassing more circumspect use of antibiotics in humans and - if resistant strains are indeed being transferred within the food chain - more restricted use of the drugs in animals. However, “every journey begins with a single step”, as the saying goes. Use of culture media that improve the identification of pathogens and thus inform the susceptibility testing process means that every laboratory can play its part.
References
1. Foxman B. Epidemiology of urinary tract infections; incidence, morbidity and economic costs. Am. J. Med. 2002; 113:55-135
2. Manges, A.R. et al. Widespread Distribution of Urinary Tract Infections Caused by a Multidrug-Resistant Escherichia coli Clonal Group. N.Eng.J.Med. 2001; 345(14):1007-1013.
3. Stamm, W.E. An Epidemic of Urinary Tract Infections? N.Eng.J.Med. 2001; 345(14):1055-1057.
4. Ramchandani, M. et al. Possible Animal Origin of Human-Associated Multidrug-Resistant, Uropathogenic Escherichia coli. Clinical Infectious Diseases. 2005; 40:251-257.
5. Warren J.W. et al. Guidelines for antimicrobial treatment of uncomplicated acute bacterial cystitis and acute pyelonephritis in women. Clin. Infect. Dis. 1999; 29:745-758.
6. Baker M. et al. Chromogenic urinary tract infection medium: evaluation and introduction for routine urine culture in a large clinical microbiology laboratory. British Journal of Biomedical Science 2001; 58(4):207-211.
By Alison Smith, Marketing Manager at Oxoid Ltd, Basingstoke, Hants.